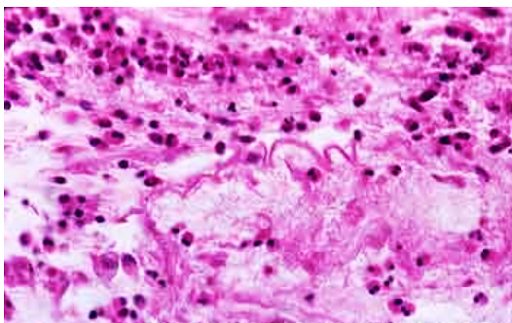

Doença crônica das vias aéreas de condução, geralmente causada por reação imunológica
Hipersensibilidade tipo I
ASMA
caracteriza-se por broncoconstrição episódica devido ao aumento da sensibilidade das vias aéreas a uma variedade de estímulos, inflamação das paredes brônquicas e aumento da secreção mucosa.
Classificação de Asma (4)
Topica, nao atopica, induzida por farmacos e ocupacional
Patogenia da Asma

Desencadeada pela ativação de linfócitos Th2 ao expor ao antígeno que passam a produzir citocinas- IL- 4 que induz a diferenciação de células B em plasmócitos gerando anticorpo IgE
Esses anticorpos vão ser reconhecidos nos receptores dos mastócitos e assim ficam revestidos por IgE - sensibilização.
Em uma segunda exposição a resposta vai ser mais rápida e assim o mastócito vai degranular e começar um processo inflamatório característico da asma.
Nos Mastócitos têm citocinas ( IL-5) que irão recrutar os eosinófilos para ativação e liberação de grânulos e mediadores - caracterizando a fase tardia.
O IL-13 vai atuar aumentando a produção de muco pelo ep respiratório.
Broncoconstrição acontece devido :
mediadores liberados pelos mastócitos
exposição das fibras colinérgicas
O ambiente inflamatório assim criado aumenta o edema da mucosa, a hiperreatividade brônquica e o broncoespasmo, caracterizada por :
Camada de músculo liso mais espessa.
A elastase neutrofílica, que induz secreção nas células caliciformes e glândulas submucosas, produzida pelos fatores de crescimento induzida pelos macrófagos, contribui para a hipersecreção brônquica.
ASMA
Características macroscópicas :
Musculatura lisa hipertrofiada
Presença de muco
Presença de hiperinsuflação do pulmão
Palidez
ASMA

Características microscópicas:
descamação epitelial
aumento do número de células caliciformes
espessamento da parede brônquica
inflamação eosinofílica
Agrupamentos com mais de 100 células epiteliais ciliadas

Corpos de Creola
Muco condensado envolto por numerosas tênues fibrilas.
Espirais de Curschmann
Precipitado encontrado no escarro decorrente da degeneração de eosinófilos (galectina-10).

Cristais de Charcot-Leyden
Sinais e sintomas:
crises agudas
dor torácica, dispneia, sibilos e tosse
*** associação com dermatite atópica


